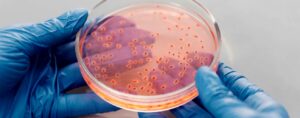

Blog SPX
Notícias e Novidades do Mundo da Saúde
Fique sempre atualizado com a notícias e novidades do mundo da Saúde com o Blog da SPX Diagnóstico por Imagem.


Como o Otorrinolaringologista Trata Sinusite e Rinite?
Condições incômodas e pertinentes para muitas pessoas, entenda de que forma o otorrinolaringologista trata sinusite e rinite


Conheça 5 Tipos de Câncer Evitáveis
Esse mal pode atingir diferentes pessoas de diferentes formas. Assim, vamos conhecer alguns tipos de câncer evitáveis a fim de se prevenir!


Como Biomarcadores podem Detectar Câncer de Próstata?
Entenda de que forma alguns biomarcadores podem detectar câncer de próstata e oferece suporte ao exame de PSA

Pesquisa Prevê Falência Precoce no Tratamento da Hanseníase
Novo modelo é capaz de identificar, com mais de 95% de precisão, falência precoce no tratamento da hanseníase de forma precoce


Estudo Detalha Relação entre Diabetes e Câncer de Mama; Veja!
Através da identificação de moléculas desregulagadas, confira as novas descobertas da relação entre diabetes e câncer de mama


Saúde em Dia: 5 Dicas para Melhorar o Sono na Terceira Idade
A qualidade do sono na terceira idade é algo a ser cuidado, uma vez que sua irregularidade pode trazer riscos à saúde!


Para Que Serve o Ultrassom Transvaginal? Entenda!
Muitas mulheres ainda se perguntam para que serve o ultrassom transvaginal. Neste artigo, vamos destacar toda a importância do exame!


Raio-X da Coluna para Dores nas Costas: O Que Pode Mostrar?
Você sabia que fazer um Raio-X da coluna para dores nas costas pode revelar muito sobre sua saúde? Entenda mais!


Estudo: Como a Dieta pode Prejudicar a Saúde Óssea?
Rica em proteínas, mas com baixas calorias, saiba como esse tipo de dieta pode prejudicar a saúde óssea e afetar a qualidade de vida